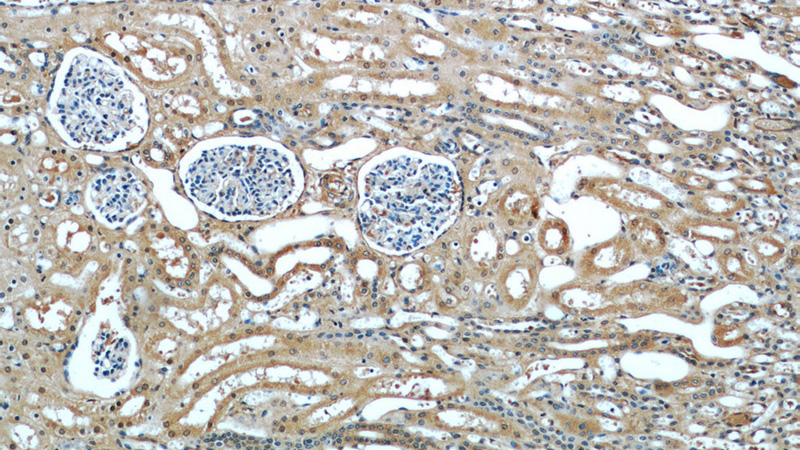
Immunohistochemical of paraffin-embedded human kidney using Catalog No:110906(GCLC antibody) at dilution of 1:50 (under 10x lens)
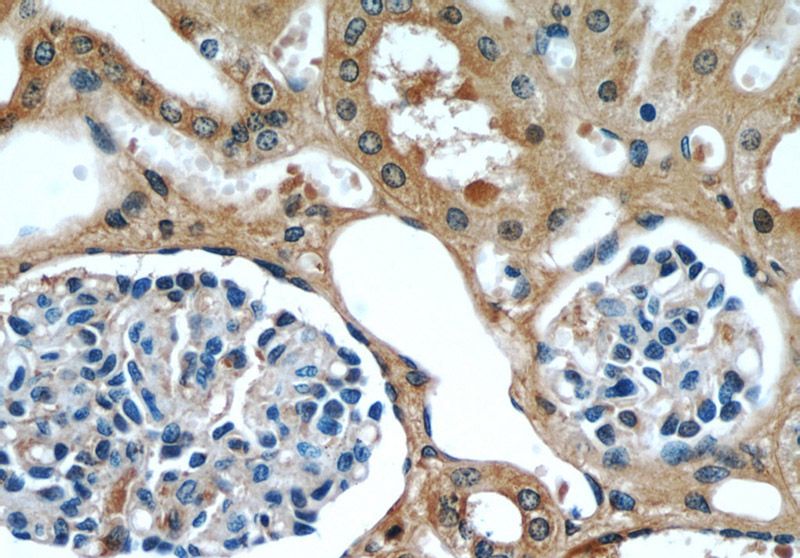
Immunohistochemical of paraffin-embedded human kidney using Catalog No:110906(GCLC antibody) at dilution of 1:50 (under 40x lens)

-
Product Name
GCLC antibody
- Documents
-
Description
GCLC Rabbit Polyclonal antibody. Positive WB detected in Jurkat cells, HEK-293 cells, L02 cells, mouse kidney tissue, mouse lung tissue. Positive IP detected in mouse kidney tissue. Positive IHC detected in human kidney tissue. Observed molecular weight by Western-blot: 73kd
-
Tested applications
ELISA, WB, IHC, IP
-
Species reactivity
Human,Mouse,Rat; other species not tested.
-
Alternative names
Gamma ECS antibody; GCLC antibody; GCS antibody; GCS heavy chain antibody; GLCL antibody; GLCLC antibody
-
Isotype
Rabbit IgG
-
Preparation
This antibody was obtained by immunization of GCLC recombinant protein (Accession Number: BC022487). Purification method: Antigen affinity purified.
-
Clonality
Polyclonal
-
Formulation
PBS with 0.02% sodium azide and 50% glycerol pH 7.3.
-
Storage instructions
Store at -20℃. DO NOT ALIQUOT
-
Applications
Recommended Dilution:
WB: 1:200-1:2000
IP: 1:200-1:2000
IHC: 1:20-1:200
-
Validations

Jurkat cells were subjected to SDS PAGE followed by western blot with Catalog No:110906(GCLC antibody) at dilution of 1:200
Immunohistochemical of paraffin-embedded human kidney using Catalog No:110906(GCLC antibody) at dilution of 1:50 (under 10x lens)
Immunohistochemical of paraffin-embedded human kidney using Catalog No:110906(GCLC antibody) at dilution of 1:50 (under 40x lens)

IP Result of anti-GCLC (IP:Catalog No:110906, 3ug; Detection:Catalog No:110906 1:500) with mouse kidney tissue lysate 4000ug.
-
Background
GCLC (Glutamate--cysteine ligase catalytic subunit) belongs to the glutamate--cysteine ligase type 3 family.It is also named as GLCL, GLCLC.It is the first rate-limiting enzyme in glutathione (GSH) biosynthesis.GCLC) gene may be associated with coronary endothelial vasomotor dysfunction and myocardial infarction (MI) (PMID:12598062). Defects in GCLC are the cause of hemolytic anemia (HAGGSD).
-
References
- Scannevin RH, Chollate S, Jung MY. Fumarates promote cytoprotection of central nervous system cells against oxidative stress via the nuclear factor (erythroid-derived 2)-like 2 pathway. The Journal of pharmacology and experimental therapeutics. 341(1):274-84. 2012.
- Zhai X, Lin M, Zhang F. Dietary flavonoid genistein induces Nrf2 and phase II detoxification gene expression via ERKs and PKC pathways and protects against oxidative stress in Caco-2 cells. Molecular nutrition & food research. 57(2):249-59. 2013.
- Wu H, Xiao Y, Zhang S. The Ets transcription factor GABP is a component of the hippo pathway essential for growth and antioxidant defense. Cell reports. 3(5):1663-77. 2013.
- Ma Q, Zhao J, Cao W, Liu J, Cui S. Estradiol decreases taurine level by reducing cysteine sulfinic acid decarboxylase via the estrogen receptor-α in female mice liver. American journal of physiology. Gastrointestinal and liver physiology. 308(4):G277-86. 2015.
- Tomasovic A, Kurrle N, Sürün D. Sestrin 2 protein regulates platelet-derived growth factor receptor β (Pdgfrβ) expression by modulating proteasomal and Nrf2 transcription factor functions. The Journal of biological chemistry. 290(15):9738-52. 2015.
- Yuan XH, Fan YY, Yang CR. Progesterone amplifies oxidative stress signal and promotes NO production via H2O2 in mouse kidney arterial endothelial cells. The Journal of steroid biochemistry and molecular biology. 155(Pt A):104-11. 2016.
- Henriques A, Croixmarie V, Priestman DA. Amyotrophic lateral sclerosis and denervation alter sphingolipids and up-regulate glucosylceramide synthase. Human molecular genetics. 24(25):7390-405. 2015.
Related Products / Services
Please note: All products are "FOR RESEARCH USE ONLY AND ARE NOT INTENDED FOR DIAGNOSTIC OR THERAPEUTIC USE"
